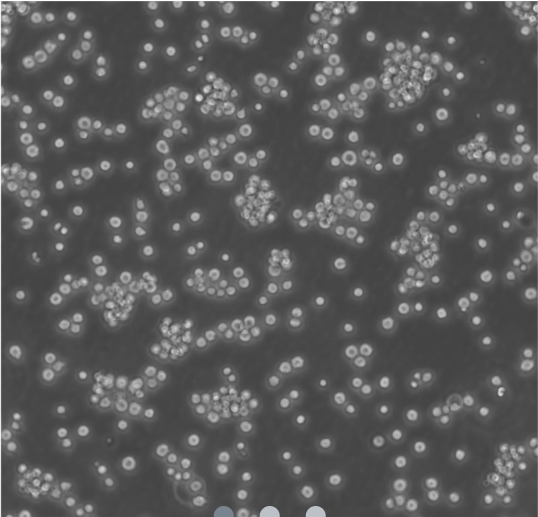

Jurkat cells are a human T-lymphocyte leukemia cell line derived from a 14-year-old with T-cell acute lymphoblastic leukemia (T-ALL). Widely used in research, they’re integral to studies on immune signaling, T-cell activation, HIV infection (via CD4 receptor), autophagy, cytotoxicity assays, and drug efficacy. Jurkat derivatives like E6.1 enhance investigations into signaling pathways and membrane dynamics.
- Abuse & The Abuser
- Achievement
- Activity, Fitness & Sport
- Aging & Maturity
- Altruism & Kindness
- Atrocities, Racism & Inequality
- Challenges & Pitfalls
- Choices & Decisions
- Communication Skills
- Crime & Punishment
- Dangerous Situations
- Dealing with Addictions
- Debatable Issues & Moral Questions
- Determination & Achievement
- Diet & Nutrition
- Employment & Career
- Ethical dilemmas
- Experience & Adventure
- Faith, Something to Believe in
- Fears & Phobias
- Friends & Acquaintances
- Habits. Good & Bad
- Honour & Respect
- Human Nature
- Image & Uniqueness
- Immediate Family Relations
- Influence & Negotiation
- Interdependence & Independence
- Life's Big Questions
- Love, Dating & Marriage
- Manners & Etiquette
- Money & Finances
- Moods & Emotions
- Other Beneficial Approaches
- Other Relationships
- Overall health
- Passions & Strengths
- Peace & Forgiveness
- Personal Change
- Personal Development
- Politics & Governance
- Positive & Negative Attitudes
- Rights & Freedom
- Self Harm & Self Sabotage
- Sexual Preferences
- Sexual Relations
- Sins
- Thanks & Gratitude
- The Legacy We Leave
- The Search for Happiness
- Time. Past, present & Future
- Today's World, Projecting Tomorrow
- Truth & Character
- Unattractive Qualities
- Wisdom & Knowledge

Comments